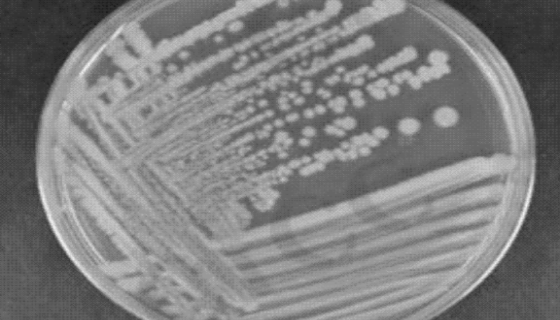
长双歧杆菌婴儿亚种的培养方法与使用范围！
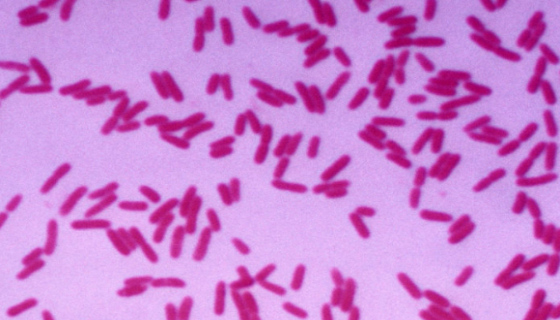
产碱假单胞菌的特点与培养及保藏方法！

大鼠甲状腺滤泡上皮细胞的培养操作与应用!
大鼠甲状腺滤泡上皮细胞的培养操作与应用!微生物菌种查询网是集...

ATCC 27958 乳房链球菌的形态特征与主要价值!
ATCC 27958 乳房链球菌的形态特征与主要价值!微生物...
长双歧杆菌婴儿亚种的培养方法与使用范围!
长双歧杆菌婴儿亚种的培养方法与使用范围!微生物菌种查询网是集...
产碱假单胞菌的特点与培养及保藏方法!
产碱假单胞菌的特点与培养及保藏方法!微生物菌种查询网是集微生...

人肝窦内皮细胞LSEC的复苏与传代操作说明!
人肝窦内皮细胞LSEC的复苏与传代操作说明!微生物菌种查询网...

枯草芽孢杆菌的作用机制及主要特性与作用!
枯草芽孢杆菌的作用机制及主要特性与作用!微生物菌种查询网是集...

ATCC 19954奥斯陆莫拉氏菌的培养方法与使用范围!
ATCC 19954奥斯陆莫拉氏菌的培养方法与使用范围!微生...

假蜜环菌的经济用途与培养条件及注意事项!
假蜜环菌的经济用途与培养条件及注意事项!微生物菌种查询网是集...

用于小麦秸秆发酵的:黄孢原毛平革菌
用于小麦秸秆发酵的:黄孢原毛平革菌,微生物菌种查询网是集微生...